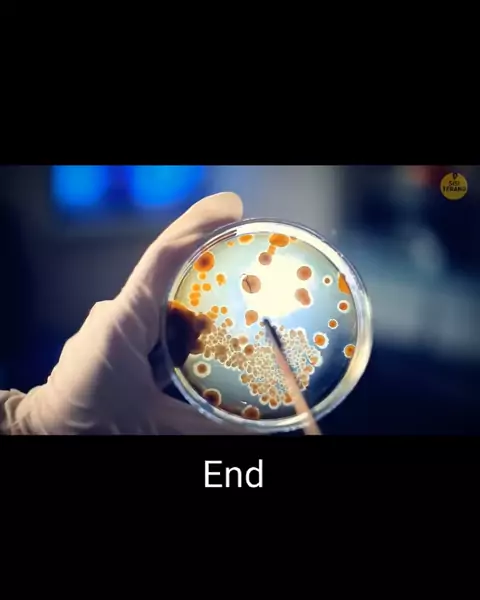

Oklinfia

958
Posts

All playlists · Total 95

3
Episode 3 #sisiterang💡 #sisiterang # #lubanghitam #luarangkasa

5
episode 1 | seputar luar angkasa #sisiterang💡 #sisiterang # #lubanghitam #luarangkasa

2
End | seputar luar angkasa #sisiterang💡 #sisiterang # #lubanghitam #luarangkasa

5
Episode 1 | seputar luar angkasa #sisiterang💡 #sisiterang # #lubanghitam #luarangkasa

4
Episode 1 #sisiterang💡 #sisiterang # #lubanghitam #luarangkasa

4
End | seputar luar angkasa #sisiterang💡 #sisiterang # #lubanghitam #luarangkasa

3
Episode 1 | seputar luar angkasa#sisiterang💡#sisiterang##lubanghitam#luarangkasa

3
Episode 1 | seputar luar angkasa #sisiterang💡 #sisiterang # #luarangkasa #lubanghitam

5
Episode 1 | seputar luar angkasa #sisiterang💡 #sisiterang # #luarangkasa #lubanghitam

5
Episode 1 | seputar luar angkasa #sisiterang💡 #sisiterang # #luarangkasa #lubanghitam

4
Episode 1 | seputar luar angkasa #sisiterang💡 #sisiterang # #luarangkasa #lubanghitam

4
Episode 1 | seputar luar angkasa #sisiterang #sisiterang # #luarangkasa #lubanghitam

5
Episode 1 | seputar luar angkasa #sisiterang💡 # # #luarangkasa #lubanghitam

3
Episode 1 | seputar luar angkasa #sisiterang💡 # # #lubanghitam #luarangkasa
9
End | seputar luar angkasa#sisiterang💡###luarangkasa#lubanghitam

5
Episode 1 | seputar luar angkasa #sisiterang💡 # # #lubanghitam #luarangkasa

4
Episode 1 | seputar luar angkasa #sisiterang💡 # # #luarangkasa #luarangkasa

4
Episode 1 | seputar luar angkasa #sisiterang💡 # # #lubanghitam #luarangkasa

4
Episode 1 | seputar luar angkasa #sisiterang💡 # # #luarangkasa #luarangkasa

4
Episode 1 | seputar luar angkasa #sisiterang💡 # # #lubanghitam #luarangkasa
























